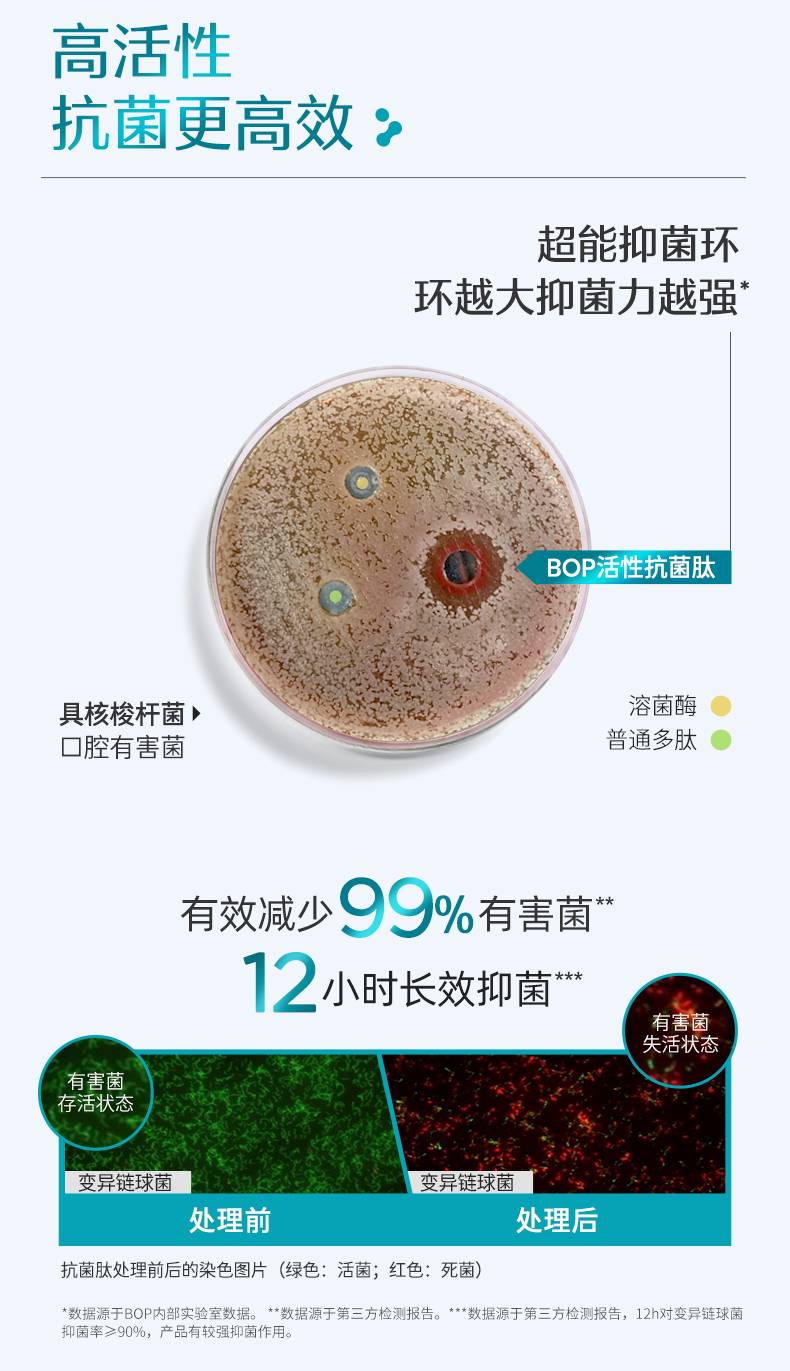

【69.9任选3件】BOP益生菌瓶装漱口水 (不满3件不发货)清新口气口臭 持久留香 漱口水 清洁口腔
¥39.80
| 运费: | ¥ 0.00-12.00 |
| 库存: | 1542 件 |
商品详情

- 尹谜
- 扫描二维码,访问我们的微信店铺